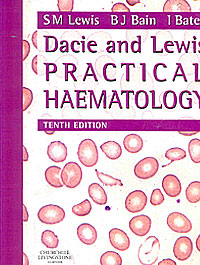

Libros: para préstamos o consultas
Los siguientes libros han ingresado en la colección del SACT:
Manual de técnicas de laboratorio en hematología / Vives Corrons, JL, Aguilar Bascompte JL. 3a ed. Barcelona, Isevier 2006. 741 p.
Contiene: 1. La sangre: características generales, métodos de extracción sanguínea y empleo de anticoagulantes. 2. La calidad en el laboratorio de hematología. 3. Origen y características morfológicas de las células sanguíneas. 4. Métodos de recuento de las células sanguíneas. 5. Recuento diferencial de leucocitos o fórmula leucocitaria. 6. La hemoglobina y sus derivados. Características generales y métodos de determinación cuantitativa. 7. Valor hematocrito e índices eritrocitarios. 8. Eritrosedimentación y otras propiedades físicas de la sangre. Pruebas funcionales isotópicas. 9. Métodos para el estudio de la médula ósea. 10. Métodos complementarios para el estudio de los leucocitos. 11. Métodos citoquímicos de estudio leucocitario. 12. Métodos inmunológicos de estudio leucocitario. 13. Métodos moleculares de diagnóstico hematológico. 14. Citogenética en el laboratorio de hematología. 15. Métodos para la clasificación de las hemopatías malignas. 16. Anemia: métodos de laboratorio para su orientación diagnóstica. 17. Métodos diagnósticos de la anemia ferropénica. 18. Métodos diagnósticos de la anemia megaloblástica. 19. Métodos diagnósticos de las hemoglobinopatías y talasemias. 20, Métodos diagnósticos de las membranopatías eritrocitarias. 21. Métodos diagnósticos de las eritroenzinopatías. 22. Métodos diagnósticos no inmunohematología. 23. Métodos diagnósticos de las citopenias inmunes. 24. Hemostasia y trombosis. 25. Métodos diagnósticos de los trastornos hemorrágicos y trombofilia. 26. Métodos diagnósticos de hemoparásitos.
Dacie and Lewis practical haematolgy / S. Mitchell Lewis, Barbara J. Brain, Imelda Bates. – 10th ed. – Philadelphia, PA. Editorial Elsevier Ltd. 2006. – xiii, 722p: il. col. : 23,5 x 19 cm.
Contiene: - Collection and handling of blood. – Reference ranges and normal values. – Basic haematological techniques. – Preparation and staining methods for blood and bone marrow films. – Blood cell morphology in health and disease. – Bone marrow biopsy. – Iron deficiency anaemia and iron overload. – Investigation of megaloblastic anaemia-cobalamin, folate, and metabolite status. – Laboratory methods used in the investigation of the haemolytic anaemias. – Investigation of the hereditary haemolytic anaemias< membrane and enzyme abnormalities. – Acquired haemolytic anaemias. – Investigation of abnormal haemoglobins and thalassaemia. – Erythrocyte and leucocyte cytochemistry. – Diagnostic radioisotopes in haematology. – Investigation of haemostasis. – Investigation of a thrombotic tendency. – Laboratory control of anticoagulant, thrombolytic, and antiplatelet therapy. – Blood cell antigens and antibodies: erythrocytes, platelets, and granulocytes 481. – Laboratory aspects of blood transfusion. – Molcular and cytogenetic analysis. – Miscellaneous tests. – Approach to the diagnosis and classification of blood diseases. – Laboratory organization and management. Laboratory safety. – Quality assurance. – Haematology in under-resourced laboratories.
|
|